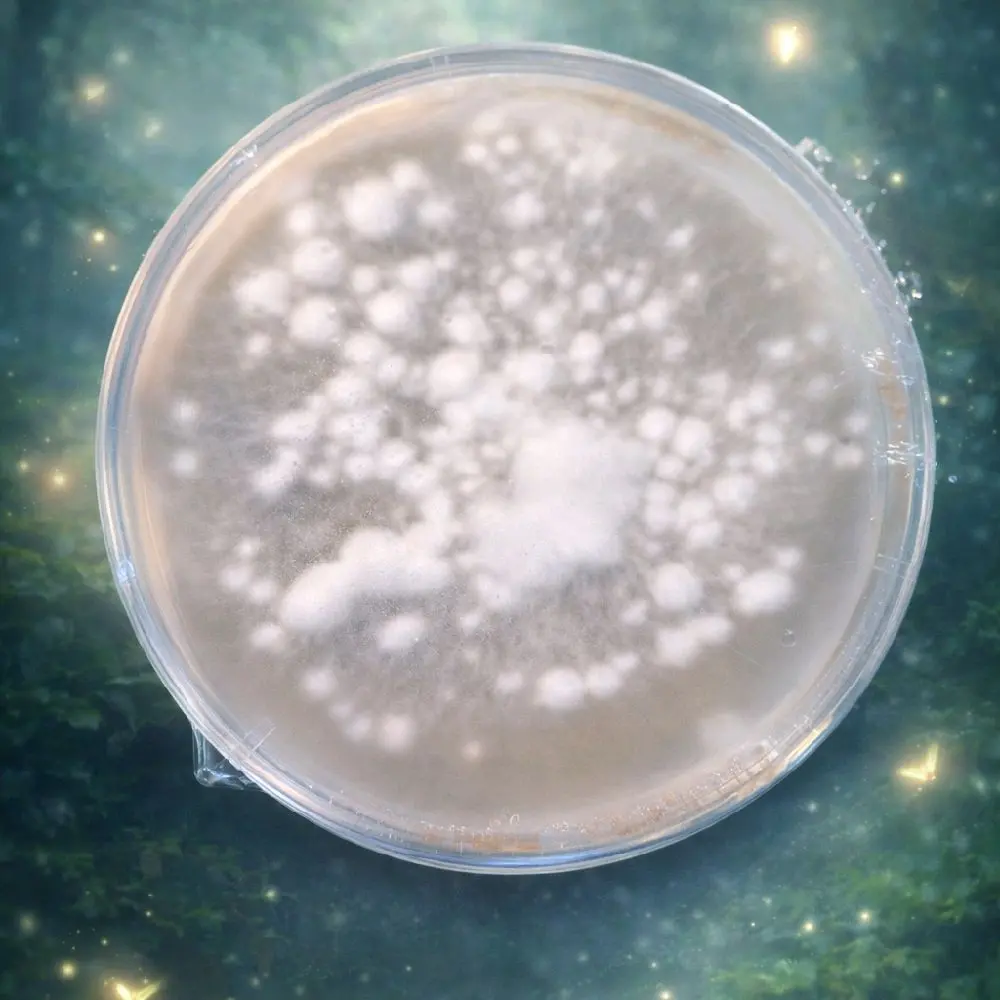

About this product
Specification:Default
Default
Quantity:
Coupon center
Log in to check your coupons
View and claim any available offers once you're logged in.
Shipping & returns
Shipping & delivery
Many items qualify for free shipping or become eligible once the order threshold is met.
Returns made easy
Most items are eligible for free returns within 30 days of delivery for a refund. Some items, including ingestibles, hygiene products, and pre-owned goods, are non-returnable. Final sale items cannot be returned or replaced. Please log in to view this item's specific return policy.
About this shop

Myco Bliss
300+ Followers
Visit
Explore more from Myco Bliss
You may also like





























Tribesigns

4.7
1.5K sold
-30%$202.83$288.12



Tribesigns

4.7
1.1K sold
-25%$215.51$288.12









Yami. Best of Asia

5.0
56 sold
-5%$8.28$8.70






RitFit

4.9
701 sold
-18%$106.05$129.62







